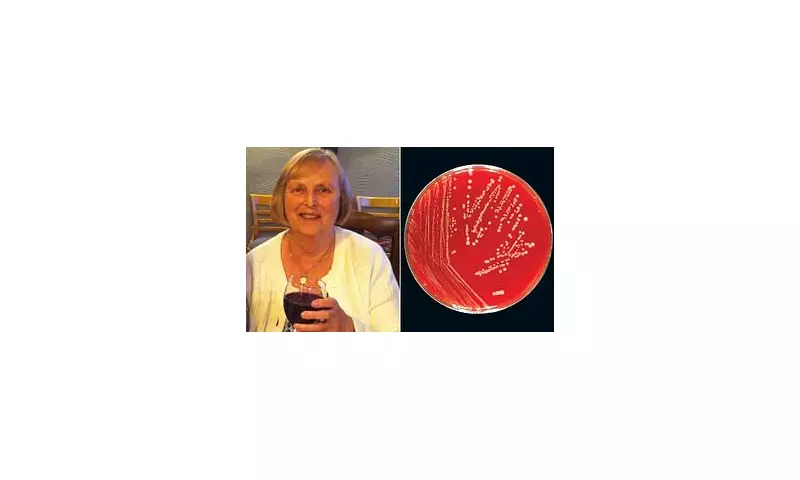
Tragic Death of Grandmother from Sepsis After Pet Dog Licked Her Wound – Inquest Reveals Shocking Details

A grandmother has tragically passed away after developing sepsis from a seemingly harmless act – her pet dog licking a small wound on her hand. The inquest into her death revealed alarming details about how quickly a minor injury can turn fatal.
How a Simple Lick Led to Tragedy
The 70-year-old woman, whose identity has not been disclosed, initially dismissed the dog's affectionate gesture as harmless. However, within days, she began experiencing severe symptoms including fever, chills, and confusion. Despite seeking medical attention, her condition rapidly deteriorated.
The Silent Danger of Pet-Related Infections
Medical experts testified at the inquest that bacteria from the dog's saliva entered her bloodstream through the wound. "Even healthy pets carry bacteria that can be dangerous to humans, especially through open wounds," explained one specialist. The coroner ruled the cause of death as sepsis secondary to the infected wound.
Warning Signs Everyone Should Know
The case has prompted health officials to remind the public about sepsis symptoms:
- High fever or low body temperature
- Extreme shivering or muscle pain
- Confusion or disorientation
- Slurred speech
- Breathlessness
Pet owners are advised to:
- Keep wounds covered when around animals
- Wash hands thoroughly after pet contact
- Seek immediate medical attention if infection signs appear
The grieving family has requested privacy but hopes their tragedy will raise awareness about this little-known danger.









